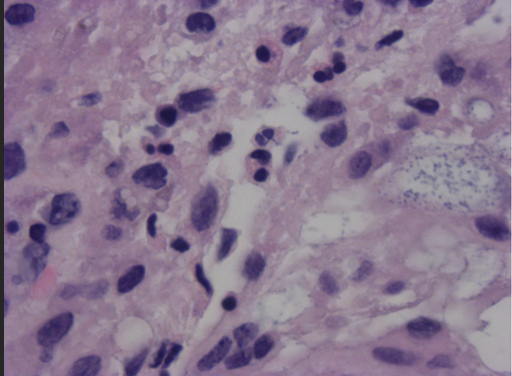
Figure 3. 100x view: High power view demonstrating atypical pleomorphic cells mixed with acute and chronic inflammatory cells.

Treating Myxoinflammatory Fibroblastic Sarcoma in a Young, Healthy Patient
Myxoinflammatory fibroblastic sarcoma (MIFS), also known as acral myxoinflammatory fibroblastic sarcoma, is a rare, usually low-grade soft tissue tumor originating in the connective tissues and mostly occurring in the distal extremities. Although it commonly presents with a distinctive morphology, MIFS can be a diagnostic challenge since it simulates other inflammatory and neoplastic conditions. It most commonly presents in adult patients in the fourth and fifth decades of life, affecting male and female patients equally, and as a slow-growing painless mass.
We present a rare and unusual case of myxoinflammatory fibroblastic sarcoma of the foot and ankle in an otherwise healthy 34-year-old woman.
What You Should Know About MIFS
MIFS is a novel and abnormal proliferation of mesenchymal tissue, usually involving the distal extremities. MIFS tumors normally present as a low-grade, slow-growing neoplasm. High-grade or dedifferentiated variants of this tumor can also occur and commonly differ from the low-grade presentations in that they have “non-enhancing areas, a non-acral location, lack of association with a tendon, and may involve bone.”1 This sarcoma belongs to a diverse category characterized by the presence of mucoid and myxoid extracellular matrices.2 Due to similar histological features in other malignancies, indistinct immunohistochemical traits within this category, and the relative novelty of MIFS discovery, the pathological classification of MIFS can be challenging, leading to difficulties in determining the most appropriate clinical treatment.3,4
Meis-Klindblom and colleagues and Montgomery and colleagues first documented MIFS in the literature in 1998. Meis-Klindblom delineated in her article these lesions were often “clinically suspected to be ganglion cysts, tenosynovitis, or giant cell tumors of the tendon sheath.”3,5 Some of the immunohistochemical characteristics that Meis-Klindblom and colleagues emphasized were the positivity for CD34 (7 of 25 patients) and focal positivity for CD68 antigen (17 of 25), but most strikingly was the strong positivity for vimentin seen in 100% of the patient samples evaluated in their initial study.3 Both Meis-Klindblom and Montgomery described the characteristic presence of extremely large and bizarre appearing cells with vesicular nuclei, with Montgomery and colleagues referring to these cells as “resembling Reed-Sternberg cells or virocytes.”5
This description of the giant cells commonly seen in MIFS appears repeatedly in subsequent studies that have since followed; however, recommendations suggest that this is limited to the microscopic description of these cells and to avoid the use of “virocytes or Reed-Sternberg–like cells” in the naming of MIFS tumors.6 This is likely to prevent confusion as to the origin of the tissue neoplasm in question, given that the cells in MIFS are epithelioid in nature, while comparators are giant cells of lymphoid origin, commonly considered pathognomonic for Hodgkins lymphoma. Although MIFS may be a diagnostic challenge, it is crucial for patient care due to local recurrence being a main complication in MIFS cases after treatment.
Laskin and colleagues evaluated the features of 104 cases of myxoinflammatory fibroblastic sarcoma with a goal of determining likely predictors of outcome. Of the 104 cases studied, “the tumor occurred in fingers, hands, and feet in 61% of cases and arose in dorsal soft tissue in 73% of cases involving distal acral sites.”7 A recent analysis of a database with 138 cases demonstrated a local recurrence rate of 22%, accompanied by a five-year probability of relapse-free survival (RFS) of 67%.8

Case Presentation: Painful Soft Tisue Mass in the Lower Extremity
A 34-year-old woman in good health underwent treatment for a painful soft tissue mass located on her left foot and ankle. Clinical examination revealed a lobular soft tissue mass on the dorsal and anterior aspects of the left foot and ankle, measuring approximately 6 x 4 cm, with tenderness upon palpation. The patient had noticed the growth of the mass 3 months prior to seeking medical attention. She had no previous medical history of similar tumors nor other illnesses.
Magnetic resonance imaging (MRI) of the left foot and ankle indicated the presence of a heterogeneously enhancing cystic and solid mass positioned anterior to the talus and navicular bones. The mass, measuring approximately 3.7 x 2.3 x 2.8 cm, exhibited an ill-defined boundary and showed no osseous involvement (Figure 1). The radiologist performing the initial read included hemangioma in the differential diagnosis.

Surgery included dissection of the subdermal layer, which revealed dark, yellowish, lipomatous and gel-like viscous tissue. The mass lacked a discernible capsule and appeared amorphous in nature. The preliminary report from the pathologist characterized the mass as having a myxoid tissue consistency of uncertain origin (Figure 2). However, there was a high suspicion for myxoinflammatory fibroblastic sarcoma. The specimen was subsequently submitted to the pathology department at Johns Hopkins University Hospital for definitive diagnosis, which indeed confirmed the presence of a myxoinflammatory fibroblastic sarcoma (Figures 3, 4, 5). A follow-up MRI after the surgery, ordered by the consulting orthopedic oncologist, revealed postsurgical changes related to the recent tumor resection along the dorsal aspect of the ankle joint. The MRI also indicated postoperative edema without the identification of any discrete drainable fluid collection.
The patient had 3 postoperative visits, showing a normal healing process. During her last visit, she mentioned that the orthopedic oncologist's treatment plan involved an initial wide excision of the area, followed by wound closure using either a split-thickness or full-thickness skin graft at a later date. At this point the prognosis for the patient looked promising. There is no further information at this point regarding any recurrence or metastasis based on the patient's reports.

What You Should Know About Myxoinflammatory Fibroblastic Sarcoma
Myxoinflammatory fibroblastic sarcoma represents an emerging pathological entity characterized by the presence of leisurely evolving soft tissue tumors predominantly localized in the distal extremities. Notably documented within the extant literature are both singular instances and collective analyses of cases pertaining to this distinctive affliction. Clinical manifestations of myxoinflammatory fibroblastic sarcoma exhibit a concordance with symptomatic profiles akin to fibromas, lipomas, ganglion cysts, and assorted inflammatory maladies.9 The cohort studies elucidate a prevalence of patients primarily within the age range spanning the fourth to sixth decades of life, with an equitable distribution across genders.7
Owing to the intricate and heterogeneous microscopic attributes associated with myxoinflammatory fibroblastic sarcoma, its diagnostic trajectory often traverses erroneous paths due to shared morphological traits with other conditions. Evident examples of such shared features include a conspicuous presence of inflammatory cell populations, analogous to Hodgkins lymphoma, and the occurrence of lipoblast-like cells reminiscent of liposarcoma, among other analogies.9 Notably, no definitive immunohistochemical markers have yet been definitively ascribed to this sarcoma.9 Prognostically, myxoinflammatory fibroblastic sarcoma is linked to a metastasis incidence of approximately 2%, a paucity of mortal outcomes, and a recurrence rate of 67%.9

Management of confirmed myxoinflammatory fibroblastic sarcoma cases mandates a wide-ranging local excision with clear margins, alongside protracted postoperative follow-up spanning up to five years.9 The surveillance focuses on detecting possible local recurrence or metastatic events. Our present discourse underscores a singular and exceptional instance of myxoinflammatory fibroblastic sarcoma, presenting a challenging diagnosis given the patient’s age and the absence of precedent occurrences or relevant comorbidities. The current state of knowledge surrounding this ailment reveals a dearth of established causative factors or discernible risk determinants, which compounds the diagnostic intricacies. The path to an accurate diagnosis remains fraught with challenges due to the nascent nature of the affliction and the conspicuous microscopic variability it entails. Thus, it is imperative for further investigative endeavors to aim at illuminating the nuances of this sarcoma and is fueled by the need to comprehend and address its remarkable propensity for recurrence.
In Conclusion
Case documentation elucidating the presence of myxoinflammatory fibroblastic sarcoma is presently constrained. These instances have predominantly undergone treatment through decisive surgery with thorough initial excision of the original mass being the greatest indicator of a good prognosis and lower recurrence rate. Analyses of case report incidents of MIFS delineate a spectrum of targeted regions within the body, although the ailment notably exhibits a propensity for manifesting in the hands and feet. The scarcity of reported cases and limited accessible data pertaining to many treatment strategies and diagnostic criteria for MIFS hinders the ability to deduce optimal approaches for disease detection and management. However, a more extensive pool of data encompassing various aspects of this condition across a diverse array of patients is imperative to advance accurate diagnosis and effective treatment of MIFS.
Dr. Ortiz is board-certified by the American Board of Foot and Ankle Surgery and the American Board of Lower Extremity Surgery.
Dr. Morales is an anatomic and clinical pathology specialist.
Student Doctor Vigo is a second-year podiatric medical student at Barry University School of Podiatric Medicine.
Student Doctor Perez is a third-year podiatric medical student at Barry University School of Podiatric Medicine.
References
1. Gaetke-Udager K, Yablon CM, Lucas DR, Morag Y. Myxoinflammatory fibroblastic sarcoma: spectrum of disease and imaging presentation. Skeletal Radiol. 2016;45(3):347-356. doi:10.1007/s00256-015-2286-2
2. Willems SM, Schrage YM, Baelde JJ, et al. Myxoid tumours of soft tissue: the so-called myxoid extracellular matrix is heterogeneous in composition. Histopathology. 2008;52(4):465-474. doi:10.1111/j.1365-2559.2008.02967.x
3. Meis-Kindblom JM, Kindblom LG. Acral myxoinflammatory fibroblastic sarcoma: a low-grade tumor of the hands and feet. Am J Surg Pathol. 1998;22(8):911-924. doi:10.1097/00000478-199808000-00001
4. Nishio J, Iwasaki H, Nabeshima K, Naito M. Cytogenetics and molecular genetics of myxoid soft-tissue sarcomas. Genet Res Int. 2011;2011:497148. doi:10.4061/2011/497148
5. Montgomery EA, Devaney KO, Giordano TJ, Weiss SW. Inflammatory myxohyaline tumor of distal extremities with virocyte or Reed-Sternberg-like cells: a distinctive lesion with features simulating inflammatory conditions, Hodgkin's disease, and various sarcomas. Mod Pathol. 1998;11(4):384-391.
6. Rastegar S, Suster D. Myxoinflammatory Fibroblastic Sarcoma. Pathology Outlines - Myxoinflammatory Fibroblastic Sarcoma, 7 Oct. 2021, www.pathologyoutlines.com/topic/softtissuemyxoinflammatory.html.
7. Laskin WB, Fetsch JF, Miettinen M. Myxoinflammatory fibroblastic sarcoma: a clinicopathologic analysis of 104 cases, with emphasis on predictors of outcome. Am J Surg Pathol. 2014;38(1):1-12. doi:10.1097/PAS.0b013e31829f3d85
8. Jagadesh N, Miller DH, Schenk W, et al. Recurrent myxoinflammatory fibroblastic sarcoma: a case report. Clin Case Rep. 2017;5(6):871-875. Published 2017 Apr 20. doi:10.1002/ccr3.949
9. Aminparast Z, Sadeghi M, Ramezani M. Report of two cases of myxoinflammatory fibroblastic sarcomas with preceding hematolymphoid neoplasms: Is there any association?. Clin Case Rep. 2022;10(7):e6065. Published 2022 Jul 18. doi:10.1002/ccr3.6065











